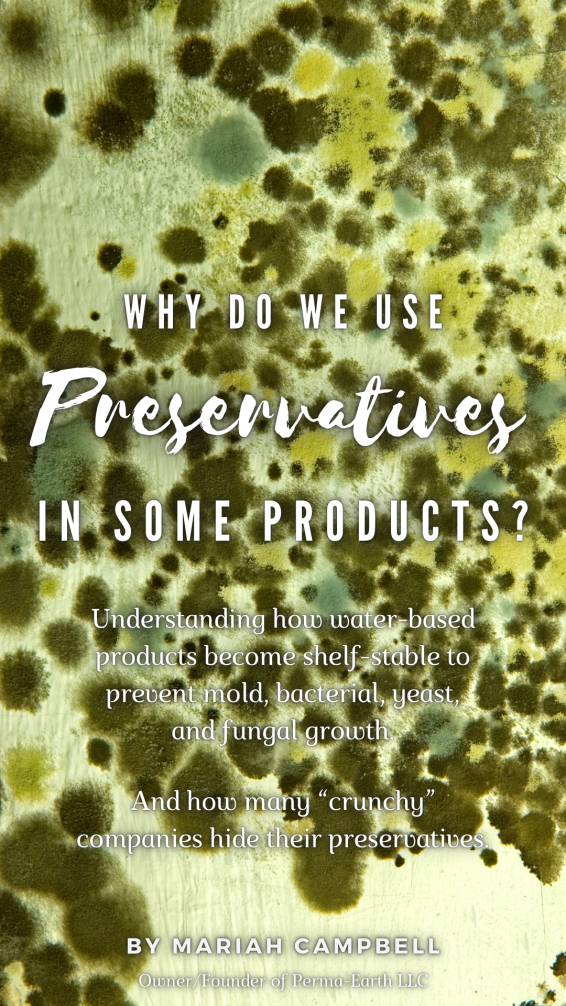

Article Topics:
Why Not Use “Natural” Preservatives?
Caution with “Extracts” as Preservatives
Why Make Any Water-Based Products?

Without water, some ingredients would be impossible to incorporate in our products. This means that without water, we would never have creams, serums, lotions, or any other liquid-based products. Active ingredients in creams and serums would not be possible. Active ingredients like hyaluronic acid, silk, aloe vera, collagen, keratin, plant extracts, caffeine, and salicylic acid are only some examples.
If you want to avoid all water-based preservatives in your bath and body routine, you can! Contact us for help, or simply avoid our products that contain any preservatives in their ingredients list. Most of our products have no water or preservatives and are shelf-stable, so this is pretty easy to do!
Why Use Any Preservatives in Water-Based Products?

Water = Life. Wherever there is water, life will grow to fill the void. This includes harmful bacteria, mold, fungus, and yeast. To prevent this water-based growth during room-temperature storage over months or years, a preservative must be added. If a preservative is not added, a water-based product will be unsafe to use in a mere matter of days.
Non-preserved water-based products need to be refrigerated between uses and completely used up within a week.
For those who want their water-based products to last longer than a week and without refrigeration, preservatives are necessary.
Why Not Use “Natural” Preservatives

Technically, we already do, as our preservatives are chemicals that are found in nature and derived from natural plants. We can simply call some of our preservatives “green tea extract” instead of “phenoxyethanol”, but is this fully honest? We don’t think so.
“Natural” is a term that is NOT legally protected. Any company can call a product “natural” without legal consequences, as everything originated from nature. At least, this is how it is in America when this article was written.
So, what’s our definition of “natural”?
We define “natural” as a substance of original form and availability found in nature which is untouched by mankind.
According to our definition, there is no such thing as a “natural” preservative. Preservatives are highly concentrated and unnatural substances. Preservatives are made by humans using what nature has to offer with various dramatic chemical processes. These chemical processes produce something that would never be naturally found in such concentrations and isolated availability.
Take alcohol for example, which can be used as a “natural” preservative. You can find a low concentration of natural alcohol inside fermented plant juices. But, this is not the same as a pure high proof spirit or cleaning alcohol. Producing something like an 8 oz bottle of 99% pure isopropyl alcohol takes extreme measures of chemical science to achieve. This is NOT something that we would consider natural. Even though the basic chemical compound of alcohol is something that is found in lower concentrations in nature.
Caution With “Extracts” as Preservatives

We don’t change our ingredient names to make them sound “better” or “more natural”. We don’t make confusing claims like so many other companies do. The cunning dishonesty in other company’s marketing styles and ingredients lists are why we’ve had to create this article. It’s also another reason why we started this company: to be more honest than the rest.
Some companies use names like “fermented radish root extract” instead of their preservative’s real chemical name. This is to hide the true preservative chemical it is: Didecyldimethylammonium chloride (DDAC) (source). And this takes some major digging to find, even for someone who is familiar with the terminology!
“Fermented Radish Root Extract” is the legal term acceptable to hide the active ingredient DDAC, for patented technology reasons. If a name purposefully hides the patented chemical concoction it is, then maybe it’s not natural? Just a thought.
The Environmental Working Group (EWG) lists DDAC (the active compound in “Fermented Radish Root Extract”) as a substance with alarming health concerns, citing potential for causing severe skin burns and eye damage. They give it a Failing grade on their safety scale, which is the lowest possible rating. https://www.ewg.org/cleaners/substances/152467-Didecyldimethylammoniumchloride/
Alternatively, the EWG rates phenoxyethanol a B on their scale, which is the second highest rating. https://www.ewg.org/cleaners/substances/4407-PHENOXYETHANOL/
This is why we use phenoxyethanol as our strongest preservative, as well as sharing the scientific name of the compound. We don’t hide it behind a crunchy name like “green tea extract” or whatever “extract” to pacify the masses.
If you have any other questions or concerns, please contact us or leave us a comment below! Thanks for reading 🙂
